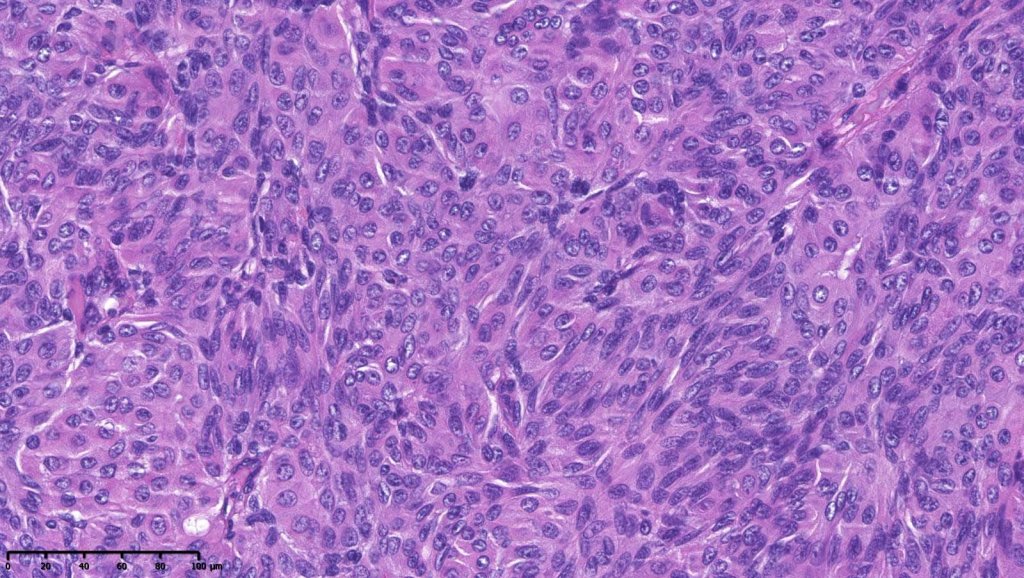
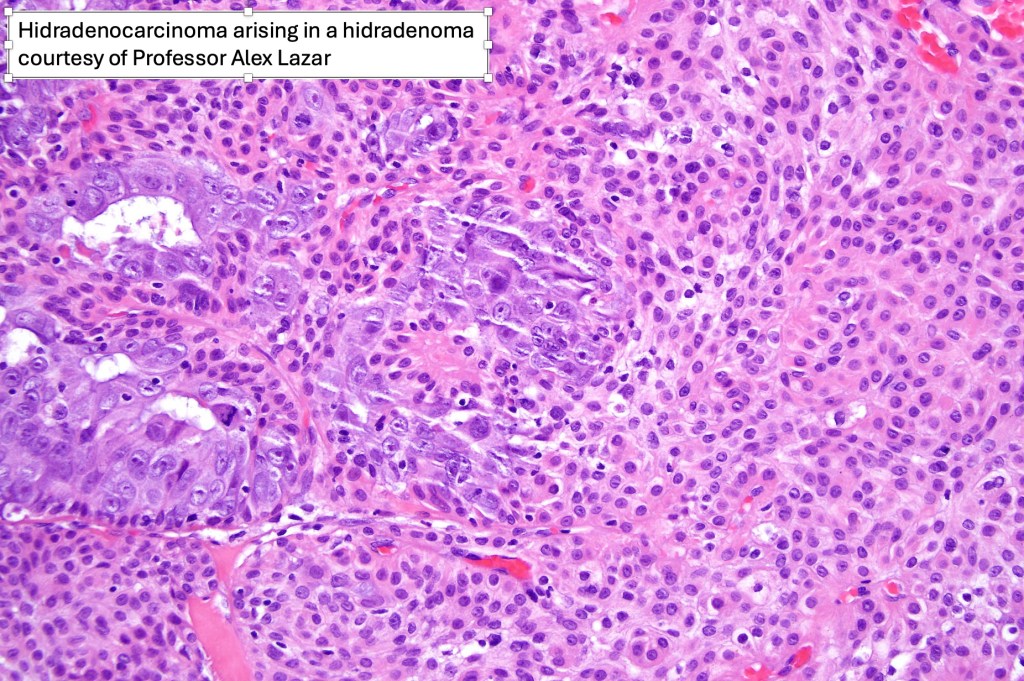

Clinical features
•Head (scalp), neck, limbs but can occur anywhere
•Slowly grown sharply circumscribed flesh colored/erythematous or blue nodule or cystic nodule 0.5-3 cm diameter
•Generally symptomatic but can be pruritic or tender
•Mostly 3rd– 5th decades (3-93 years)
•Slight predominance in females

Histological features
•Solid or cystic sharply defined nodule in dermis sometimes extending into subcutaneous fat
•Eccrine (predominantly poroid & cuticular cells) & apocrine variants (association with a follicle, decapitation secretion & GCDFP-15+ve)
•May overlap with poroma
•Generally composed of an admixture of small eosinophilic cells & glycogen-rich larger clear cells
•Round to oval vesicular nuclei with small nucleoli or hyperchromatic nuclei
•No pleomorphism & scanty or no mitoses
•Ductal and glandular differentiation
•Squamous differentiation
•Goblet cells are not uncommon
•Rarely sebaceous differentiation
•Pigmented variant
•Hyaline collagenous stroma
•Atypical variant- nuclear pleomorphism, hyperchromatism, giant cells & increased mitotic activity (use very sparingly as risk of underdiagnosis of carcinoma is very high!)
•Lymphovascular invasion with regional lymph node spread in an otherwise benign appearing hidradenoma should be treated with extreme caution despite a good prognosis having been suggested (see case below)

Leave a comment